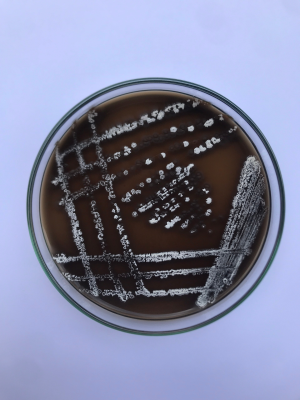
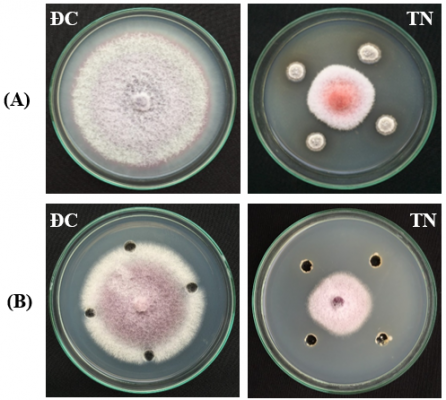

Chuối có nguồn gốc từ Đông Nam Á, được trồng rộng rãi ở khắp các vùng nhiệt đới và cận nhiệt đới. Bởi vì chuối giàu dinh dưỡng và tinh bột nên được coi là cây lương thực quan trọng thứ tư sau gạo, lúa mì và ngô để giảm nạn đói của con người ở châu Phi bởi Tổ chức Nông lương Liên hợp quốc. Năm 2019, sản lượng chuối trên toàn thế giới là hơn 113 triệu tấn; hai nước trồng chuối lớn nhất là Ấn Độ (36,7%) và Trung Quốc (13,8%). Tuy nhiên, bệnh héo vàng do nấm Fusarium oxysporum f. sp. cubense (Foc) là một trong những loại bệnh gây hại nặng nề nhất đối với chuối, gây thiệt hại lớn về kinh tế trong thời gian dài. Đặc biệt, chủng Foc 4 nhiệt đới (Foc TR4) có thể lây nhiễm vào hơn 80% các giống chuối. Bệnh hại này đã được tìm thấy ở các vùng sản xuất chuối lớn của các vùng nhiệt đới và cận nhiệt đới. Ở Việt Nam, chủng Foc TR4 gây hại trên chuối tiêu, chuối tây xuất hiện nhiều vùng trồng chuối ở các tỉnh Vĩnh Phúc, Phú Thọ, Hưng Yên, Lào Cai, Hà Nội. Việc quản lý hiệu quả và lâu dài đối với bệnh héo vàng trên chuối vẫn còn thách thức, phần lớn là do cây ký chủ lâu năm và nấm bệnh tồn tại lâu trong đất. Hiện nay, phương pháp được sử dụng phổ biến nhất để kiểm soát bệnh héo vàng trên chuối là biện pháp sử dụng thuốc hóa học để tiêu diệt trực tiếp mầm bệnh trong đất. Ưu điểm của việc kiểm soát hóa học là nhanh chóng, tiết kiệm, đơn giản và hiệu quả trong thời gian ngắn. Tuy nhiên các đặc tính của đất và sự đa dạng của vi sinh vật sẽ bị phá hủy do sử dụng hóa chất trong thời gian dài. Ngoài ra còn tiềm ẩn những nguy cơ về môi trường và an toàn thực phẩm. Các biện pháp nông nghiệp để kiểm soát bệnh như luân canh, cải tạo đất tiêu tốn rất nhiều thời gian, công sức và không phù hợp với các vườn chuối thâm canh hiện đại quy mô lớn. Chính vì thế, nhóm tác giả thuộc Trung tâm Sinh học Thực nghiệm, Viện Ứng dụng Công nghệ và khoa Công nghệ sinh học, Học viện Nông nghiệp Việt Nam đã thực hiện nghiên cứu đặc tính đối kháng với nấm fusarium oxysporum gây bệnh trên chuối của chủng xạ khuẩn streptomyces sp. Vnua27
Sau khi nghiên cứu các đặc điểm khuẩn lạc, chủng xạ khuẩn VNUA27 được nghiên cứu xác định thời gian hình thành, hình dạng chuỗi sinh bào tử và bào tử. Kết quả quan sát dưới kính hiển vi quang học cho thấy, chủng xạ khuẩn VNUA27 bắt đầu hình thành cuống sinh bào tử sau 36 giờ nuôi cấy. Các bào tử được sắp xếp thành chuỗi dài, dạng xoắn và sau 48 giờ bắt đầu đứt rời khỏi chuỗi, phát tán. Quan sát dưới kính hiển vi điện tử quét (SEM) ở độ phóng đại 2.000 lần cho thấy rõ, hình thái chuỗi sinh bào tử của chủng VNUA27 rất đặc trưng với dạng xoắn màu trắng, mỗi chuỗi hình thành 20-35 bào tử (Hình 1).

Hình 1. Hình thái chuỗi sinh bào tử của chủng xạ khuẩn VNUA27 dưới kính hiển vi điện tử quét (SEM)
ở độ phóng đại 2.000 lần
Xạ khuẩn tổng hợp và hình thành sắc tố melanin được coi là một tiêu chí chuẩn để phân loại. Kết quả sau 7 ngày nuôi cấy chủng xạ khuẩn VNUA27 trên môi trường ISP6 cho thấy màu của môi trường chuyển trừ màu vàng nhạt sang màu nâu đen, chứng tỏ chủng VNUA27 có khả năng sinh sắc tố melanin (Hình 2). Các hợp chất melanin được xạ khuẩn sinh ra có tác dụng bảo vệ chúng khỏi bức xạ tia cực tím. Đặc biệt, melanin từ xạ khuẩn đã được nghiên cứu cho thấy có nhiều hoạt tính sinh học bao gồm hoạt động chống oxy hoá, đặc tính kháng khuẩn.
Hình 2. Kết quả kiểm tra khả năng hình thành melanin của chủng VNUA27 khi nuôi cấy
trên môi trường ISP-6 sau 7 ngày
Xạ khuẩn được sử dụng như tác nhân kiểm soát sinh học chống các bệnh truyền nhiễm qua đất. Khả năng đối kháng với các vi sinh vật gây bệnh của xạ khuẩn được cho là nhờ các hợp chất thứ cấp có hoạt tính sinh học. Các chất này được xạ khuẩn tiết ra môi trường trong quá trình nuôi cấy. Do đó, hoạt tính kháng nấm của chủng VNUA27 được đánh giá bằng phương pháp đồng nuôi cấy và khuyếch tán trên đĩa thạch. Kết quả quá trình nuôi cấy đã xác định được chủng VNUA27 có khả năng đối kháng mạnh với nấm Foc TR4, cho tỉ lệ phần trăm đối kháng là 54.78%1.35 khi đồng đồng nuôi cấy (Hình 3A) và 46.01% 1.06 khi tiến hành thử nghiệm khuếch tán đĩa thạch (Hình 3B). Kết quả này cho thấy chủng VNUA 27 có tỉ lệ kháng nấm Foc TR4 tốt, cao hơn rất nhiều so với chủng S. griseorubiginosus có tỉ lệ kháng nấm Foc là 37.05 % đã được công bố bởi Cao & cs., 2005. So sánh với nghiên cứu gần đây nhất, chủng VNUA27 cho kết quả kháng nấm tương đương với chủng SCA 2-4 có tỉ lệ kháng nấm Foc TR4 là 53.17% khi đồng nuôi cấy và 42.47 % khi khuếch tán đĩa thạch bằng sử dụng dịch chiết xuất (6.25 ) tách từ chủng SCA 2-4.
Hình 3. Hoạt tính kháng nấm Foc TR4 của chủng VNUA27 bằng phương pháp đồng nuôi cấy (A) và phương pháp khuếch tán đĩa thạch (B)
Như vậy, bệnh héo vàng chuối do nấm Fusarium oxyspoum f. sp. cubense (Foc) gây thiệt hại nặng nề nhất đối với chuối. Đặc biệt, chủng Foc TR4 có thể lây nhiễm hầu hết các giống chuối. So với các biện pháp truyền thống, biện pháp sinh học sử dụng vi sinh vật trong phòng trừ bệnh được coi là biện pháp chiến lược. Trong nghiên cứu này, chủng xạ khuẩn VNUA27 được phân lập, đánh giá khả năng đối kháng với nấm Foc TR4. Đánh giá ảnh hưởng của dịch nuôi cấy chủng xạ khuẩn VNUA27 đến sự phát triển của hệ sợi và nảy mầm của bào tử nấm Foc TR4. Trên cơ sở nghiên cứu các đặc điểm hình thái, sinh lý, sinh hóa và phân tích vùng trình tự 16S rARN chủng xạ khuẩn VNUA27 đã được xác định là Streptomyces diastatochromogenes VNUA27. Kết quả nghiên cứu cho thấy, chủng xạ khuẩn VNUA27 đối kháng mạnh với nấm Foc TR4 (54.78%. Sợi nấm Foc TR4 sau khi được xử lý bằng dịch nuôi của chủng VNUA27 bị co lại và biến dạng. Các mẫu bào tử của nấm Foc TR4 được xử lý bằng dịch nuôi của chủng xạ khuẩn VNUA27 cho thấy một tỉ lệ lớn bào tử không nảy mầm (ức chế 82.42%). Đặc biệt, nghiên cứu này đã phát hiện ra gen chức năng KSα tham gia vào quá trình sinh tổng hợp các chất chuyển hóa thứ cấp của chủng VNUA27. Kết quả nghiên cứu cho thấy, chủng xạ khuẩn VNUA27 là chủng tiềm năng giúp phòng trừ nấm Foc TR4 đạt hiệu quả cao bằng biện pháp sinh học.
Thông tin chi tiết truy cập tại: https://tapchi.vnua.edu.vn/wp-content/uploads/2022/08/tap-chi-so-8.5.pdf
Đào Hương – NXB Học viện

